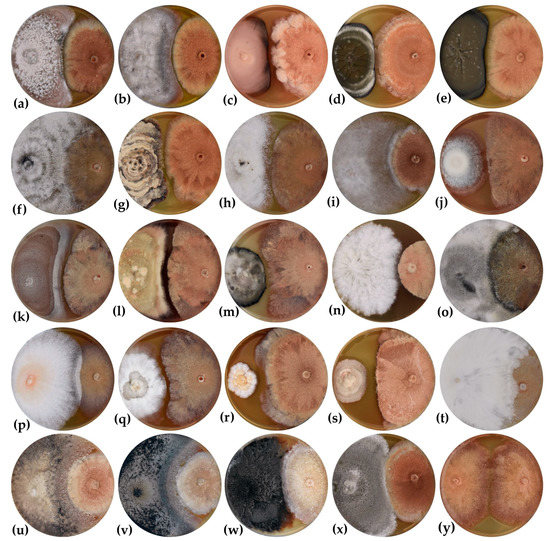

Abstract
The species diversity of culturable endophytic fungi was studied in the leaves and twigs of symptomatic and asymptomatic Fraxinus excelsior trees. Endophytic mycobiota was dominated by Ascomycota species, with Pleosporales (44.17%) and Diaporthales (23.79%) endophytes being the most frequently observed in the tree samples. The number of endophytic isolates and species richness varied depending on the sampling date (May and October) and tissue location. Of the 54 species identified based on ITS sequences, 14 were classified as dominant. The most frequently isolated species were Diaporthe eres, followed by Alternaria alternata, Dothiorella gregaria, and Fraxinicola fraxini. The inhibitory effect of 41 species (75 isolates) of endophytes on the radial growth of a Hymenoscyphus fraxineus isolate was studied under in vitro conditions (dual cultures). The radial growth of H. fraxineus was the most inhibited by four endophytic fungi from twigs (Fusarium lateritium, Didymella aliena, Didymella macrostoma, and Dothiorella gregaria). The inhibitory effect of the four isolates was also studied under in planta conditions. The isolates artificially inoculated into the trunks of ash trees reduced the length of necroses formed by H. fraxineus co-inoculated in the same trunks. This effect depended on the isolate, and the inhibition was most prominent only on trunks inoculated with F. lateritium and D. aliena. Although the total length of necrotic lesions formed by the H. fraxineus infection was shorter in the ash trunks co-inoculated with the endophytes, the difference was not significant.
1. Introduction
European ash (Fraxinus excelsior) plantations throughout Europe have been devastated by the fungal pathogen Hymenoscyphus fraxineus, causing ash dieback disease since the 1990s. Investigation into the etiology of F. excelsior decline in Europe has revealed a rich community of other fungal species. Few species are very common, and many occur only sporadically. In addition to H. fraxineus, ash branches and leaves are colonized by other parasitic and saprophytic fungi [1,2,3,4,5], which are secondary invaders of tissue weakened or dying from ash dieback. Frequently occurring fungi include Alternaria alternata, Diaporthe eres, Diplodia mutila, Epicoccum nigrum, Fusarium spp., and Phomopsis spp. The fungus Phyllactinia fraxini, which causes powdery mildew disease [6], is the most common foliage pathogen of ash trees. Plagiostoma fraxini (anamorph Discula fraxinea) causes anthracnose disease in ash trees grown in relatively cool regions [7,8]. Wood-inhabiting fungal communities in ash trees include species such as Auricularia mesenterica, Bjerkandera adusta, Inonotus hispidus, Perenniporia fraxinea, and Ganoderma spp., causing white rot and wood degradation [9,10]. Armillaria species (Armillaria cepistipes, A. gallica) attack the roots of ash trees and cause root and butt rot [11].
In Slovakia, Pastirčáková et al. [12] recorded a wide spectrum of parasitic and saprophytic species of fungi commonly colonizing ash trees, but H. fraxineus was the most widespread species in the country [13]. Hymenoscyphus fraxineus causes dieback of F. excelsior in Europe, but in its native East Asian range, it is typically a harmless endophyte in the leaves of several Fraxinus species [14,15,16].
Endophytes can be characterized in a variety of ways [17], but in general, they are microorganisms that spend at least part of their life cycle inside plant tissues without generating visible symptoms or damage to their hosts [18]. A single plant can harbor many endophytic organisms [19]. Fungal endophytes that asymptomatically colonize plants have the capacity to promote host plant growth and can play an important role in increasing host plant tolerance to abiotic stress, plant pests, and pathogens [20,21,22,23,24]. Endophytic fungi are also active against pathogenic fungi. Endophytes Alternaria sp., Cladosporium sp., Fusarium sp., and Penicillium sp. from Aristotelia chilensis and Embothrium coccineum significantly inhibited the growth of the common fungal pathogen Botrytis cinerea [25]. An endophytic isolate of Trichoderma koningiopsis from Hevea guianensis inhibited the causal agent of Corynespora leaf fall disease (Corynespora cassiicola), both in culture and in plants [26]. Several studies have already been published on the endophytic microbiome of ash in recent years, and the protective effects of some endophytic fungi against the ash dieback pathogen have also been studied [27,28,29,30,31,32,33,34]. Although endophytes that inhibit H. fraxineus in vitro (e.g., Boeremia exigua, Botrytis cinerea, Clonostachys rosea, Epicoccum nigrum, Nemania diffusa, N. serpens, Peniophora cinerea, Phoma macrostoma, Rosellinia corticium, Setomelanomma holmii, and Xylaria polymorpha) [28,29,34] are promising candidates for a biocontrol agent for ash dieback, their efficacy should be verified by in planta tests because the in planta situation is more complex [35]. Preliminary research has revealed that Hypoxylon rubiginosum has an antagonistic effect on H. fraxineus in planta trials [31]. Little is known about the endophytic mycobiome of ash trees in Slovakia. Only a few endophytes (Alternaria alternata, Dothiorella sarmentorum, and Fusarium oxysporum) colonizing F. excelsior branches and leaves have been recorded [12,36,37]. However, there is a need to further characterize and study endophytic fungi in ash trees to understand their potential role in the biocontrol of ash dieback disease.
The aims of this study were to (i) characterize species diversity of culturable fungal endophytes in leaves and twigs from symptomatic and asymptomatic F. excelsior trees in spring and autumn, (ii) evaluate interactions between ash dieback pathogen H. fraxineus and isolated endophytes in vitro (dual cultures), and (iii) evaluate the inhibitory effect of antagonistic endophytes under in planta conditions.
2. Materials and Methods
2.1. Fungal Cultures
The strain of H. fraxineus (D27) used in this study was isolated from necrotic lesions on twigs of F. excelsior collected in central Slovakia (locality of Duchonka; 48°42′53″ N, 18°02′33″ E) in 2015 [38,39]. Malt extract agar (MEA) supplemented with 50 g/L of frozen healthy ash (F. excelsior) leaflets removed after autoclaving [40], was used to isolate and grow the H. fraxineus strain and for a dual culture bioassay. MEA supplemented with Rose Bengal 10 mg/L and antibiotics (streptomycin sulphate 50 mg/L, penicillin G 50 mg/L; both added after autoclaving) was used for fungal endophyte isolation. All of the media were autoclaved at 120 °C for 20 min, and 20 mL per plate was poured into polystyrene Petri dishes (90 × 16 mm). The fungal cultures were incubated at 25 ± 1 °C in darkness.
2.2. Study Sites and Sampling
The collection of ash samples for fungal endophyte analyses was carried out in an F. excelsior forest (17.03 ha; with 5% of Robinia pseudoacacia as an admixture species) in the locality of Jarok (southwestern Slovakia, 48°16′38″ N, 17°57′51″ E). The forest was attacked by ash dieback, which was confirmed by direct observations of disease symptoms on trees (necrotic lesions on leaflets and petioles, dieback of branches, and sporadically whole tree crowns dead) and by H. fraxineus apothecia presence on ash leaf petioles from the previous year on the forest floor. In total, 20 trees showing symptoms of ash dieback disease and 20 asymptomatic trees were selected for sampling on 14 May and 14 October 2019. On each sampling date, 5 leaves and 5 twigs (only those that looked healthy) were collected from 10 symptomatic and 10 asymptomatic trees. Altogether, 100 leaves and 100 twigs (two years old) were collected on each sampling occasion. The individual samples were placed in polyethylene zipper bags and stored at 5 °C overnight.
2.3. Isolation of Fungal Endophytes
Collected leaves/twigs were processed for the isolation of fungal endophytes the next day. Under aseptic conditions, 5 leaflets of individual leaf samples and a 40 mm segment of each twig were surface-disinfected (96% ethanol for 1 min, followed by 2.5% sodium hypochlorite for 5 min and 3× rinses in sterile distilled water for 1 min) and dried shortly on sterilized tissue wipes (modified after Ibrahim et al. [41]). A single 10 mm diameter leaf disc was cut off from the central part of each surface-disinfected leaflet (including a midrib) by a cork borer. Five 5 mm sections were cut from the disinfected twigs. The leaf discs and twig sections were placed on the surface of the MEA plate and incubated in the dark at 25 ± 1 °C. In total, isolations were performed from 500 fragments of 100 leaves and 500 segments of 100 twigs. The plant fragments were checked daily, and all endophytic colonies were aseptically transferred to fresh MEA plates and cultivated for 10 days. Most cultures were transferred twice to obtain pure cultures. About 10% of cultures needed 3–4 transfers. Fungal colonies on agar plates were characterized as endophytic only if mycelia grew from internal plant tissue at the edge of plant sections. The quality of the surface-disinfection method was assessed by plating three replicates of the residual third rinse water (500 µL) on MEA plates. A three-week incubation at 25 ± 1 °C resulted in no fungal colonies on these plates, which confirmed the efficacy of the disinfection procedure. Pure cultures of endophytes were used for molecular species identification, and identified cultures were included in a dual culture bioassay. The colonization rate (CR) of the tissue samples by endophytic fungi was calculated using the formula by Kumar and Hyde [42]:
where EI is the number of endophytic isolates obtained from the particular tissue sample (leaf or twig), and SS is the number of tissue sections from the tissue sample tested for endophytes on the surface of the MEA plate.
%CR = EI/SS × 100,
2.4. Molecular Identification of Endophytes
DNA was extracted from two-week-old cultures using the EZ-10 Spin Column Fungal Genomic DNA Kit (Bio Basic Inc., Markham, ON, Canada) according to the manufacturer’s instructions. The internal transcribed spacer (ITS) region of the ribosomal RNA gene was amplified using the primer combinations ITS1F/ITS4 [43,44] and ITS4/ITS5 [43]. PCR conditions for the primer pair ITS1F/ITS4 were set as reported by Kádasi Horáková et al. [45]. The amplification reaction conditions for primers ITS4/ITS5 included initial denaturation at 95 °C for 14 min, followed by 30 cycles of denaturation at 95 °C for 25 s, annealing at 56 °C for 50 s, elongation at 72 °C for 90 s, and final extension at 72 °C for 10 min. The PCR mix consisted of approximately 10 ng of template DNA, 10 pmol/µL of forward and reverse primers, 5x HOT FIREPol® Blend Master Mix (Solis Biodyne, Tartu, Estonia), and deionized water of molecular grade (Pro injection, B. Braun). All PCRs were performed in a total volume of 20 μL in Bio-Rad T100TM Thermal Cycler (Bio-Rad Laboratories Inc., Hercules, CA, USA). The PCR products were visualized on 1% (w/v) TBE agarose gel stained with a SimplySafe stain (EURx, Gdansk, Poland). The target PCR fragments were purified using the QIAquick PCR Purification Kit (Qiagen, Hilden, Germany). Sequencing was performed in both directions using an ABI PRISM 3130 (Applied Biosystems, Waltham, MA, USA) by SEQme Ltd. (Dobříš, Czech Republic). The retrieved sequences were processed using SnapGene® Viewer 5.0.7 (GSL Biotech LLC, San Diego, CA, USA) and compared by BLASTN ver. 2.13.0+ [46] against ITS sequences deposited in the NCBI GenBank database.
2.5. Dual Culture Bioassay
In total, 75 fungal endophytes were screened for their capacity to suppress the growth of H. fraxineus (strain D27) in a dual culture bioassay on MEA (supplemented with ash leaflets) in Petri dishes (90 × 16 mm). Mycelial plugs (5 mm in diameter) of the actively growing margins of the H. fraxineus and endophyte colonies were placed at a fixed distance of 55 mm on the MEA plates. The plugs were placed at the opposing end of the same Petri dish. Due to the slower growth rate of H. fraxineus compared to the endophytes, H. fraxineus plugs were first cultured for four days at 25 °C, and on the fifth day, plugs of endophytes were placed on the MEA plates [47]. Dual culture tests of six slow-growing endophytic isolates (TA31-4M, TA55-5M, TA93-1M, TS94-4M, LS25-1M, and LS42-3M) were started simultaneously with the H. fraxineus strain on the MEA plates. Ten control plates were inoculated in a similar manner, but two plugs of H. fraxineus were placed in Petri dishes without endophytes. The plates for all combinations of H. fraxineus and endophytes were incubated at 25 ± 1 °C in the dark. The interactions between the dual culture partners were checked at three-day intervals, and the radii of colonies were measured using a digital caliper on day 27 post-inoculation. Each combination of the H. fraxineus strain and the endophytic isolates was performed in triplicate. Inhibition of radial growth of the H. fraxineus strain by the endophytes in dual cultures was evaluated by the inhibition index of radial growth (IRG), calculated using the following formula:
where R1 is the radius of the H. fraxineus colony from the control Petri dishes, and R2 is the radius of the H. fraxineus colony measured on the line between the inoculation positions of the H. fraxineus strain and the endophyte in the dual culture plates. The radial growth of the H. fraxineus colony was inhibited by the co-culturing endophyte when the IRG value was greater than zero. The higher the IRG value within the range of 0–1, the greater the inhibition effect of the endophyte.
IRG = (R1 − R2)/R1,
Interactions between colonies of H. fraxineus and endophytes were also visually assessed, and the following interaction types [48] were recognized: physical contact of mycelia in which neither isolate was able to overgrow the other (A), H. fraxineus colony partially overgrown by an endophyte after initial deadlock with mycelial contact (B1), H. fraxineus colony overgrown by an endophyte without initial deadlock (B2), an endophyte colony overgrown by H. fraxineus (C), an inhibition zone present between the colonies with the width of <2 mm (D1), the inhibition zone was >2 mm (D2).
2.6. Field Bioassay
Inoculation experiments were conducted on 5-year-old F. excelsior trees grown in the experimental area of the Institute of Forest Ecology SAS in Nitra. The experimental trees had an average trunk diameter of 15.4 mm at the inoculation point. Inoculations were performed with one isolate of H. fraxineus (strain D27) and four isolates of endophytes exhibiting inhibitory activity in a dual culture bioassay (TS105-4M—Didymella aliena, TA63-2O—Didymella macrostoma, TA52-5M—Dothiorella gregaria, and TS94-4M—Fusarium lateritium). For inoculum production, sterilized discs (4 mm in diameter) of F. excelsior sapwood were colonized with fungal isolates on MEA plates for 3 weeks [49]. Inoculations of the trees were carried out in the tree trunk (ca. 40 cm from the base of the trunk) on 21 April 2021. Two holes (4 mm in diameter) were drilled by a cork borer in the bark tissue at a distance of 2 cm. The holes were patched with the colonized discs, one colonized with an endophyte isolate, and one colonized with H. fraxineus. The endophyte was inoculated upward. Combinations of H. fraxineus strain with each endophytic isolate were inoculated in four replicates. As a negative control, a single sterile non-colonized disc was applied to the trunk, whereas an H. fraxineus-colonized disc was applied to the trunk as a positive control. In the case of positive and negative controls, three replicate inoculations were performed. The discs were then covered with parafilm. Parafilm wrapping was removed after 30 days. Together, 34 trees were inoculated. The host’s response to the fungal isolates was measured by the formation of a callus or necrotic tissue at 30-day intervals. The length of superficial necrosis on the bark was measured in the acropetal and basipetal directions from the inoculation point. All experimental trees were cut down 180 days after inoculation (on 18 October 2021) and transported to the laboratory for analysis. After the bark tissue was removed, the length of the cambial necrosis was measured. The tree trunk was cut at the inoculation point, and the depth of necrosis was measured.
Two samples of wood tissue, each approximately 5 × 5 mm, were taken from the margin of necrosis that formed after inoculation of H. fraxineus on all experimental trees. The samples were used to confirm the presence of H. fraxineus in the tissue. The samples were homogenized in liquid nitrogen, and the total genomic DNA was extracted according to the manufacturer’s protocol using the EZ-10 Spin Column Fungal Genomic DNA Kit. DNA was suspended in 50 µL of elution buffer and stored at −20 °C. The identity of H. fraxineus was confirmed by species-specific primers targeting the 18S gene and the ITS-2 region of the rDNA operon [50]. The PCR components and conditions were in accordance with Pastirčáková et al. [51].
2.7. Data Analysis
Chi-square tests were performed to determine if the colonization rate by endophytic fungi was affected by the tissue type (leaf and twig), the health condition of the studied trees (symptomatic and asymptomatic), and from the sampling time (May and October). The Shannon and Simpson diversity indices [52,53] were used to determine the diversity of fungal endophytes found in ash tree samples. Species dominance was estimated for each species of fungal endophyte according to Camargo [54]. A species was considered dominant if its relative abundance was higher than 1/S, where S denotes species richness. IRG data from the dual culture bioassay were arcsine transformed () before analysis of variance (ANOVA) was used to determine differences among fungal endophytes. If significant differences were detected, the post hoc Tukey HSD test (p = 0.05) was performed. All statistical analyses were performed using Minitab 17® (© 2013 Minitab Inc., State College, PA, USA).
3. Results
3.1. Endophytic Mycobiota in Ash Leaves and Twigs
Altogether, 400 tissue samples (2000 tissue sections) were cultured from the leaves and twigs of 40 ash trees. Endophytic fungi grew from all of the examined trees, and 799 tissue sections (39.95%) yielded fungal colonies. The colonization rate (CR) of samples by endophytes varied depending on the tissue type, the health status of the trees, and from the date of sampling (Table 1). The mean CR of the different tissue types ranged from 13.6 to 72.0%. The lowest rate of colonization was observed in leaves sampled in May, whereas the highest CR was detected in twigs collected in May. Chi-square analysis identified a significant difference in CR between leaves and twigs collected from both symptomatic (Χ2(1,N=500) = 63.51, p < 0.001) and asymptomatic trees (Χ2(1,N=500) = 30.29, p < 0.001). This was observed regardless of the sampling date, and twigs were colonized by endophytes at a significantly higher rate than leaves in May (Χ2(1,N=500) = 392.71, p < 0.001), but more endophytes were retrieved from leaves than twigs in October (Χ2(1,N=500) = 40.14, p < 0.001). However, the health status of the sampled trees had no significant effect on the CR of leaf (Χ2(1,N=500) = 3.51, p = 0.061) and twig samples (Χ2(1,N=500) = 0.42, p = 0.517). The date of sampling was a significant factor in retrieving endophytes from the trees. A significantly higher CR was detected for leaf samples collected in October from both symptomatic (Χ2(1,N=500) = 66.59, p < 0.001) and asymptomatic trees (Χ2(1,N=500) = 171.96, p < 0.001), but the twig samples were significantly more colonized in May (Χ2(1,N=500) = 73.63, p < 0.001 for asymptomatic trees and Χ2(1,N=500) = 62.78, p < 0.001 for symptomatic trees).

Table 1.
Isolation of endophytic fungi on malt extract agar plates from different types of tissue samples collected from Fraxinus excelsior in Slovakia in 2019.
Altogether, 1007 isolates of endophytic fungi were obtained from the analyzed ash trees. The number of isolates obtained was not uniformly distributed across the collected samples and was dependent on the sampling date, tree health, and tissue type (Table 1). The highest number of isolates was retrieved from the twigs collected in May (197 and 198 isolates from asymptomatic and symptomatic trees, respectively) and the asymptomatic leaves sampled in October (179 isolates). The lowest number of cultures was isolated from the leaves in May. The mean number of isolates per tissue sample (twig or leaf) varied from 0.7 to 4.0 (Table 1) with a significant difference (F(7,72) = 15.57, p < 0.001) among sample types, sampling dates, and the health status of trees. For example, leaf samples collected in May yielded significantly fewer isolates than twig samples on the same collection date or leaf samples in October (Figure 1). The sampling date was an important factor in obtaining endophytes from a particular tissue type. In October, a significantly higher mean number of isolates was recovered from leaves than in May, whereas more isolates were obtained from twigs in May than in October.

Figure 1.
Box and whisker plot showing the mean number of isolates of endophytic fungi per tissue sample (leaves or twigs) of ash trees displaying (symptomatic) or not displaying (asymptomatic) symptoms of ash dieback disease collected in May and October 2019; mean values indicated by the same letter are not significantly different (Tukey HSD test; p = 0.05).
Based on macromorphological characteristics, 206 endophytic isolates were selected for molecular identification, 199 isolates were identified at the species level, 5 isolates were determined at the genus level, and 2 isolates could only be placed in the order rank (Table 2). Endophytic mycobiota isolated from the tissue samples comprised 54 species from 42 genera and 13 orders. Sequences of four isolates provided a BLAST match with the GenBank database of less than 98% and might therefore be different taxa than those listed in Table 2. Interestingly, H. fraxineus was not isolated from the tissue samples of symptomatic trees using the isolation method employed in this study. The numbers of species varied depending on the sampling dates (May and October) and tissue locations (leaf and twig) (Figure 2). As many as 43 endophytes were detected in either from leaves or twigs, and 16 endophytes were identified in both tissue types. On both sampling dates, 20 endophytes were detected. Twelve endophytes were detected in both tissue types and on both sampling dates.

Table 2.
Endophytic fungi identified from leaves and twigs of ash trees displaying (symptomatic) or not displaying (asymptomatic) symptoms of ash dieback disease collected in Slovakia in May and October 2019.

Figure 2.
Venn diagram showing the number of identified endophytes shared among different sampling dates (May and October) and tissue locations (leaf and twig) on Fraxinus excelsior.
The mycobiota of the endophytes from the ash tissue were significantly dominated by Ascomycota (205 isolates, 99.51%) and included 13 orders. One isolate was identified as Hygrophorus sp. (Agaricales) from Basidiomycota, however, with a low percent identity (78.49%) after BLAST in the GenBank database. Therefore, the identity of this isolate must be considered doubtful. Pleosporales endophytes were the most frequently identified (91 isolates, 44.17%) from the tissue samples, and this order was the most species-rich (29 species, 49.15%), followed by Diaporthales, with 23.79% of relative isolate frequency (49 isolates) and six species (10.17%) (Figure 3c). The remaining fungal orders were represented by ≤5 species and ≤18 isolates. Relative frequencies of isolates by taxonomic order and percentage proportions of species numbers in particular orders were similar on both sampling dates (Figure 3a,b). Although the number of fungal orders discovered in May and October was comparable (11 orders in May vs. 12 orders in October), the structure of the identified orders varied. On both sampling dates, Pleosporales was the most species-rich order (19 species in May and 20 species in October). Diaporthales was the second most abundant order. Although only six Diaporthales species were detected in May, the relative frequency of isolates reached 33.33% (38 isolates), which was higher than the relative frequency of the Pleosporales isolates (29.82%, 34 isolates). Diaporthales were less abundant in October (11 isolates, 11.58%) than in May. While Amphisphaeriales and Eurotiales (each represented by a single species) were only detected in May, Helotiales, Mycosphaerellales, and Agaricales (each represented by a single species) were detected only in October. The species richness in the genera was variable. The most species-rich genus, Diaporthe, was represented by five species; Cladosporium, Alternaria, and Didymella were each represented by three species (Table 2). Most genera (29) were represented by a single species. Of the 54 identified species, 14 were classified as dominant. Diaporthe eres was the most frequently isolated species (25 isolates in May, and 4 isolates in October), followed by Alternaria alternata (6 isolates in May, and 20 isolates in October), Dothiorella gregaria (8 isolates in May, and 4 isolates in October), and Fraxinicola fraxini (8 isolates in May, and 1 in October).

Figure 3.
Relative frequency of isolates by taxonomic order and percentage proportions of species number in a particular order to the overall number of isolated species; (a) analysis of isolates from May 2019; (b) analysis of isolates from October 2019; (c) total number of isolates in 2019.
The species diversity indices calculated for all samples in May reached 0.925 and 3.152 for Simpson’s (D) and Shannon’s (H) indices, respectively, and they were similar to the indices for samples collected in October (D = 0.929; H = 3.232) (Table 2). The highest diversity indices were recorded for endophyte populations in asymptomatic leaves in May (D = 0.934; H = 2.471), and the lowest values were recorded for symptomatic leaves in May (D = 0.722; H = 1.525).
3.2. Inhibitory Effect of Endophytes against H. fraxineus on Artificial Medium
As many as 75 isolates of 41 species of endophytic fungi were tested for their inhibitory effect on the radial growth of H. fraxineus in dual cultures. Various types of mycelial interactions were observed between the H. fraxineus isolate and the endophytic fungi after 27 days of co-incubation on MEA (Table 3, Figure 4). The most frequent type of interaction was the formation of an inhibition zone between the co-partners in the dual cultures. This interaction type was observed for 49 endophyte isolates (31 species). The width of the inhibition zone depended on the endophyte isolates. It was greater than 2 mm (D1 interaction type) for 25 isolates and less than 2 mm (D2 interaction type) for 24 isolates. The largest mean zone of growth inhibition was formed around the colonies of Phoma herbarum (9.33 mm) and Phaeosphaeria sp. (8.67 mm), both isolated from asymptomatic twigs collected in October. The H. fraxineus colony was overgrown by 20 isolates (13 species) of endophytic fungi, 14 isolates (9 species) partially overgrew the H. fraxineus colony after an initial deadlock with mycelial contact (B1 interaction type), and 6 isolates (4 species) overgrew H. fraxineus without an initial deadlock (B2 interaction type). The capacity of H. fraxineus to grow over endophyte colonies was also observed (C interaction type). Such a situation was observed for one isolate of Sporormiella minima (Figure 4w) when the H. fraxineus isolate partly overgrew the edge of the endophyte colony. The interaction of five isolates of endophytic fungi from leaves resulted in physical contact with the colony of H. fraxineus (A interaction type). In this case, neither the endophyte nor H. fraxineus could overgrow the co-partner after mutual contact of mycelia. There was no observed variation in the interaction type between replicates of the same isolate; however, isolates of the same species could form different types of interactions with H. fraxineus, e.g., Didymella aliena isolates: LS25-3O type B1, TS105-4M type D1, and TS43-1M and LS102-1M type D2. In the dual culture experiment, the inhibitory effect of endophytes on the radial growth of H. fraxineus was observed for 57 isolates (35 species). The radius of H. fraxineus colonies adjacent to their endophytic co-partners was reduced compared to that in the control. The mean inhibition index (IRG) varied significantly (F(56,114) = 6.37, p < 0.001) among the endophytes (Table 3). The IRG values for most endophytes (52 isolates) did not exceed 0.25. The highest value of IRG was observed for Fusarium lateritium isolate TS94-4M, reaching 0.575 ± 0.017. The radial growth of H. fraxineus was the most reduced by four endophytic isolates from twigs (TS94-4M Fusarium lateritium, TS105-4M Didymella aliena, TA63-2O Didymella macrostoma, and TA52-5M Dothiorella gregaria) (Table 3). These isolates were selected for the in planta bioassay. Eighteen endophytic isolates (17 species) did not show an inhibitory effect on the growth of H. fraxineus. In this case, the radius of the H. fraxineus colonies was greater in the dual cultures than in the control.

Table 3.
Inhibitory effect of endophytic fungi on the radial growth of Hymenoscyphus fraxineus in a dual culture experiment.
Figure 4.
Mycelial interactions after 27 days of co-incubation between the isolate of Hymenoscyphus fraxineus (right) and selected isolates of endophytic fungi (left): (a) Alternaria infectoria, (b) Ascochyta medicaginicola, (c) Aureobasidium pullulans, (d) Cladosporium allicinum, (e) Cladosporium tenuissimum, (f) Diaporthe eres, (g) Diaporthe oncostoma, (h) Diaporthe rudis, (i) Didymella aliena, (j) Didymella macrostoma, (k) Dothiorella gregaria, (l) Epicoccum nigrum, (m) Fraxinicola fraxini, (n) Fusarium lateritium, (o) Hypoxylon fragiforme, (p) Lepteutypa fuckelii, (q) Microdiplodia sp., (r) Neofabraea vagabunda, (s) Phaeosphaeria sp., (t) Rosellinia corticium, (u) Sordaria fimicola, (v) Sordaria lappae, (w) Sporormiella minima, (x) Stemphylium vesicarium, (y) control—two plugs of H. fraxineus taken from the same colony.
3.3. In Planta Evaluation of the Inhibitory Effect of Endophytes
Four endophytic isolates from ash twigs of symptomatic (TS94-4M Fusarium lateritium and TS105-4M Didymella aliena) and asymptomatic (TA63-2O Didymella macrostoma and TA52-5M Dothiorella gregaria) trees that inhibited the H. fraxineus strain on MEA plates were selected for the in planta bioassay. The endophytic isolates used to artificially inoculate the trees formed no necroses, and the wounds made on the bark during inoculation were covered by protective callus tissue and were almost totally regenerated 180 days after inoculation (Figure 5b). The same situation was observed in the negative control when the trees were treated with sterile, non-colonized discs. Following H. fraxineus inoculation, typical ash dieback lesions appeared surrounding the inoculation points (Figure 5a). The necrotic lesions developed on the surface of the bark and in the wood tissue. The length of superficial necroses developed on the bark by the artificially inoculated H. fraxineus isolate (Figure 6a) varied depending on whether (the positive control) endophytic fungal isolates were co-inoculated on the experimental trees. Necroses were shorter on trees co-inoculated with endophytes TS94-4M and TS105-4M ( = 24.25 ± 4.77 and 17.50 ± 4.29, respectively) than on trees inoculated only with H. fraxineus ( = 34.00 ± 12.50 mm). This indicates a suppressive effect of the endophytes on H. fraxineus growth and corresponds with the results of the in vitro bioassay. However, the difference in necrosis length was not significant (F(2,8) = 1.305, p > 0.05). No suppressive effect on H. fraxineus was observed in trees inoculated with the endophytic isolates TA63-2O and TA52-5M. The lesions were of the same length ( = 34.00 ± 12.29 mm) or longer ( = 37.25 ± 8.41 mm) than lesions in the positive control.

Figure 5.
Necrotic lesions on the stems of five-year-old Fraxinus excelsior trees developed 180 days after their artificial inoculation with Hymenoscyphus fraxineus (Hf) and endophytic fungi Didymella macrostoma (TA63-2O), Dothiorella gregaria (TA52-5M), Fusarium lateritium (TS94-4M), and Didymella aliena (TS105-4M): (a) necroses developed after inoculation of the bark with H. fraxineus alone (the positive control) or in combination with endophytic fungal isolates including cross-sections through the ash stems at the inoculation points; (b) trees recovered from wounds performed on the bark of ash trees during inoculation with endophytic fungal isolates, including non-inoculated tree (the negative control).

Figure 6.
Box and whisker plots showing the length of superficial (a) and cambial (b) necroses developed by artificially inoculated Hymenoscyphus fraxineus on the bark of ash trees colonized or not colonized (control) by selected endophytic fungal isolates (TA63-2O—Didymella macrostoma, TA52-5M—Dothiorella gregaria, TS94-4M—Fusarium lateritium, TS105-4M—Didymella aliena).
The lengths of superficial necroses (on the bark) were shorter than the lengths of cambial necroses (Figure 6a,b), but the difference was not significant (p > 0.05). The average length of cambial necroses in the positive control reached 39.83 ± 14.61 mm, and the necroses on the experimental trees co-inoculated with the endophytes TS94-4M and TS105-4M were shorter (25.75 ± 4.46 mm and 17.75 ± 4.27 mm, respectively) than the control necrosis.
The necroses did not develop evenly above or below the inoculation points. On average, the length of necrosis in the acropetal direction (to the endophyte inoculation point) was shorter by 79.26 ± 18.37% (superficial necroses) and 75.25 ± 14.69% (cambial necroses) than the length in the basipetal direction (Figure 5a). However, the difference was not significant (F(1,30) = 3.734, p > 0.05 for superficial necroses, and F(1,30) = 3.304, p > 0.05 for cambial necroses). The growth of necroses depended on co-inoculated endophytes. Necroses on experimental trees co-inoculated with isolates TA52-5M and TS94-4M grew evenly in both directions, while necroses on trees co-inoculated with TA63-2O and TS105-4M grew predominantly in the basipetal direction. Necrotic wood depth at the inoculation point reached the pith of the tree trunk (Figure 5a), and the mean depth varied from 5.25 ± 0.25 mm to 7.50 ± 2.25 mm, depending on the co-inoculated endophytes.
The presence of H. fraxineus was confirmed in all necrotic lesions by species-specific PCR, which produced an amplicon of 456 bp.
4. Discussion
The results of this study revealed high species variability of culturable fungal endophytes in leaves and twigs from asymptomatic and symptomatic ash trees. Species from Pleosporales and Diaporthales were the most common endophytes, which corresponds to the findings of earlier research on endophyte diversity in ash trees in Europe [4,29,55]. Only limited information is available on fungal endophytes in ash trees in Slovakia [12,36,37], and this work considerably expanded the existing data. Most endophytic fungi identified in this study are not host-specific, e.g., Alternaria alternata, Cladosporium cladosporioides, and Epicoccum nigrum, and only two are strictly host-specific fungi, namely, Diplodia fraxini and Fraxinicola fraxini. The generalists were anticipated to predominate in the analyzed samples because the method of tissue examination for endophytes favored this group of fungi. Nemania serpens, Diaporthe eres, Venturia fraxini (a synonym for Fraxinicola fraxini), and Diaporthe sp. were the most frequent endophytes found in the leaf petioles of F. excelsior in Poland, as shown in a recent study [34]. Regardless of tissue type, the species structure of the most frequent endophytes identified from the ash trees in this study was different. Although D. eres was also the most frequently isolated species, F. fraxini and N. serpens were recovered from only nine leaf samples or a single twig sample, respectively. This discrepancy is possible because endophyte communities are not equal throughout the leaf tissue. For example, Schlegel et al. [56] discovered considerable variations in endophyte communities between leaf petioles and leaf laminae of ash and maple trees. It was evident that D. eres dominated in twig samples in May, whereas the second most frequent endophyte, A. alternata, was more prevalent in leaf and twig samples collected in October. The colonization frequency and species richness of endophytes increased with the age of leaf tissue but slightly decreased with the age of twig tissue. These differences may reflect the short life span of the leaves, and the nutrient composition and physiochemical variations between these two environments. We presume that leaf endophytes are transmitted horizontally, and that leaf colonization exists via infections directly from the environment, particularly in the case of generalist species that predominate in the analyzed samples. Different species of fungi require different lengths of time to produce spores, colonize tissue, and establish themselves in the hosts. Therefore, the colonization rate and species richness were lower in the samples collected in the spring (May) than in the fall season (October). It is generally accepted that the colonization rate of plant tissues by endophytic fungi increases with tissue age. Numerous studies have observed this finding [57,58,59,60]. In contrast to the leaf samples, the rate of colonization in twigs did not increase during the season but decreased. The decrease was more prominent in twigs from symptomatic trees, and we presume that ash dieback disease has a negative effect on endophyte colonization. The species diversity indices calculated for both sampling dates were similar to those observed by Bilański and Kowalski [34] for endophytes in the leaf petioles of F. excelsior. The diversity increased slightly with the age of the leaves, but not with the age of the twigs.
Factors influencing the abundance and diversity of endophyte communities in woody plants have recently been discussed in detail by Sieber [61]. Because the identification of endophytes in this study was limited to culturable fungi, the true diversity and abundance of the endophytic community in the ash trees remained undiscovered. Many nonculturable and obligate biotrophic species could not be detected by the method used to examine endophytes in ash tree samples. Another important selection factor was the use of only one type of agar medium for endophyte isolation. However, we expect that incorporating ash leaf extract into the cultivating medium might facilitate the isolation of species that have closer interactions with the host trees. Slower-growing endophytic fungi could be outcompeted or inhibited in the medium by faster-growing species, and to eliminate this effect, Rose Bengal was used to retard the growth of fast-growing species [62], while allowing slower-growing fungi to emerge from ash tissues. Culture-dependent techniques tend to favor dominant endophytic fungi [63], and rarer species with irregular occurrences in ash trees might be missed with only two sampling occasions. Due to the limitations of the methodology used in this study, it is possible that a range of potential candidate endophytes with biocontrol capabilities was overlooked.
Fungal endophytes may interact with host plants in manifold ways, and a potential protective effect against plant pathogens is one of them [63,64]. The use of endophytic microorganisms to control plant pathogens is receiving increasing attention as a sustainable alternative to synthetic pesticides. In the last decade, the mutual relationships between endophytes and plant hosts have been studied to understand the effects of endophytes on plant pathogens and their potential use for biological control. The endophyte-based biocontrol strategy is not a novel idea and has been studied in many agricultural and horticultural crops [65,66,67]. Treatment of trees with endophytes with the purpose of inhibiting the development of plant-pathogenic fungi is also under consideration [21,63,68,69,70]. Recently, several studies have been published that have determined the antagonistic potential of fungal endophytes against H. fraxineus [27,29,34,71]. This study confirmed the antagonistic activity of several local endophytic isolates against H. fraxineus in a dual culture bioassay. The strongest antagonistic effect was observed for F. lateritium, D. aliena, D. macrostoma, and D. gregaria. The antagonistic effect was coupled with the production of a wide inhibition zone in the cases of F. lateritium, D. macrostoma, and D. gregaria, which indicated a release of metabolites into the culture medium with an inhibitory effect against H. fraxineus growth. In a similar dual culture experiment, F. lateritium was listed among five endophytes with the strongest inhibition effect against H. fraxineus [34]. This fungus is also known as a natural antagonist of the plant pathogen Eutypa armeniacae (synonym of Eutypa lata), causing sapwood necrosis in fruit trees, grapevines, and ornamental plants [72]. However, F. lateritium is known as a globally distributed plant pathogen and has been reported in approximately 180 hosts, mainly woody plants, where it causes wilt, tip, or branch dieback, and cankers [73,74]. Dothiorella gregaria is also linked to branch and trunk canker in several plants [75]. However, the Didymella genus mainly includes saprobes commonly found in living or dead parts of plants [76]. In a recent study, another endophyte from the ash tree Hypoxylon rubiginosum appeared to be a promising biocontrol endophyte with strong fungitoxic properties and an antagonistic effect on H. fraxineus in planta [31]; however, it is also a mild pathogen, sometimes causing cankers on plants, including ash trees [77]. In other in vitro bioassays, different endophytes demonstrated inhibitory effects against isolates of H. fraxineus. For example, Sclerostagonospora sp., Setomelanomma holmii, Epicoccum nigrum, Boeremia exigua, and Fusarium sp. [29] or Plenodomus biglobosus and Paracucurbitaria corni [71] inhibited the growth of H. fraxineus in dual cultures. The inhibitory effect on the germination of H. fraxineus ascospores has also been documented for several leaf endophytes isolated from F. excelsior, e.g., Fraxinicola fraxini, Paraconiothyrium sp., Boeremia exigua, Kretzschmaria deusta, Pezicula sp., Neofabraea alba (synonym of Neofabraea vagabunda), and Ampelomyces quisqualis [27].
Although several studies have confirmed the antagonistic effect of fungal endophytes against H. fraxineus under in vitro conditions, their effect under in planta conditions has not yet been verified. Laboratory studies may not be good predictors of biocontrol agents’ protective capacity, and, unfortunately, most research on tree pathogen–endophyte interactions has been conducted in the laboratory. It is uncertain how the interactions would change in the face of changing environmental conditions and existing competition with other species in the tree ecosystem; therefore, in planta bioassays are necessary. Moreover, the modes of action of most endophytes as biocontrol agents are still unknown, and bioassays on host plants may explain them. For example, the antagonistic effect of fungal endophytes on trunk necrosis development has already been documented in plants. Endophytic Trichoderma aureoviride used to inoculate the trunk was able to significantly reduce the necrosis size compared to the control on 30-year-old beech trees artificially inoculated with Phytophthora plurivora [69]. We evaluated the trunk inoculations of the four endophytic isolates, showing a strong inhibitory effect in the laboratory against inoculated H. fraxineus. Although the total length of necrotic lesions formed by the H. fraxineus infection was shorter in the ash trunks co-inoculated with the endophytes than in the trunks without the endophytes, the difference was not significant. The presence of H. fraxineus was confirmed in the necrotic lesions on all trunks (inoculated and non-inoculated with endophytes) six months after inoculation, which demonstrated that the endophytes could not eliminate the pathogen. The effect of endophytes on the development of necrosis was most prominent in the direction of the inoculation points of Didymella macrostoma and Didymella aliena. The weakest effect on H. fraxineus was Dothiorella gregaria. Although trunk inoculations did not produce optimistic results in this research, trunk inoculation with endophytes against phytopathogens has potential. It is likely that some fungal species can stimulate the ash’s immune system against H. fraxineus infection, and this supports the importance of further research in the fight against this pernicious pathogen.
Author Contributions
Conceptualization and methodology, K.P., M.K.H. and M.B.; formal analysis, K.P., M.K.H. and M.B.; investigation, K.P., M.K.H., M.B., R.O. and M.K.; data curation, K.P. and M.K.H.; writing—original draft preparation, K.P., M.K.H. and M.B.; writing—review and editing, K.P., M.K.H., M.B., R.O. and M.K.; visualization, K.P., M.B. and R.O.; supervision, K.P. and M.K.H.; project administration and funding acquisition, M.K.H. All authors have read and agreed to the published version of the manuscript.
Funding
This research was funded by the Scientific Grant Agency of the Ministry of Education, Science, Research and Sport of the Slovak Republic and the Slovak Academy of Sciences, grant number VEGA 2/0062/18.
Data Availability Statement
Sequences generated during this study were deposited in GenBank.
Acknowledgments
We would like to thank the anonymous reviewers for their useful and insightful comments on the manuscript.
Conflicts of Interest
The authors declare no conflict of interest. The funders had no role in the design of the study; in the collection, analyses, or interpretation of data; in the writing of the manuscript; or in the decision to publish the results.
References
- Przybyl, K. Fungi associated with necrotic apical parts of Fraxinus excelsior shoots. For. Pathol. 2002, 32, 387–394. [Google Scholar] [CrossRef]
- Bakys, R.; Vasaitis, R.; Barklund, P.; Thomsen, I.M.; Stenlid, J. Occurrence and pathogenicity of fungi in necrotic and non-symptomatic shoots of declining common ash (Fraxinus excelsior) in Sweden. Eur. J. For. Res. 2009, 128, 51–60. [Google Scholar] [CrossRef]
- Kowalski, T.; Czekaj, A. Symptomy chorobowe i grzyby na zamierających jesionach (Fraxinus excelsior L.) w drzewostanach Nadleśnictwa Staszów. Leśne Pract. Badaw. 2010, 71, 357–368. [Google Scholar] [CrossRef]
- Kowalski, T.; Kraj, W.; Bednarz, B. Fungi on stems and twigs in initial and advanced stages of dieback of European ash (Fraxinus excelsior) in Poland. Eur. J. For. Res. 2016, 135, 565–579. [Google Scholar] [CrossRef] [Green Version]
- Cross, H.; Sønstebø, J.H.; Nagy, N.E.; Timmermann, V.; Solheim, H.; Børja, I.; Kauserud, H.; Carlsen, T.; Rzepka, B.; Wasak, K.; et al. Fungal diversity and seasonal succession in ash leaves infected by the invasive ascomycete Hymenoscyphus fraxineus. New Phytol. 2017, 213, 1405–1417. [Google Scholar] [CrossRef] [PubMed]
- Braun, U.; Cook, R.T.A. Taxonomic Manual of Erysiphales (Powdery Mildews), 1st ed.; CBS Biodiversity Series 11; CBS: Utrecht, The Netherlands, 2012; 707p. [Google Scholar]
- Sinclair, W.A.; Lyon, H.H.; Johnson, W.T. Diseases of Trees and Shrubs, 1st ed.; Cornell University Press: Ithaca, NY, USA, 1987; 575p. [Google Scholar]
- Mejía, L.C.; Castlebury, L.A.; Rossman, A.Y.; Sogonov, M.V.; White, J.F. A systematic account of the genus Plagiostoma (Gnomoniaceae, Diaporthales) based on morphology, host-associations, and a four-gene phylogeny. Stud. Mycol. 2011, 68, 211–235. [Google Scholar] [CrossRef]
- Ryvarden, L.; Melo, I. Poroid Fungi of Europe, 2nd ed.; Synopsis Fungorum 37; Fungiflora A/S: Oslo, Norway, 2017; 430p. [Google Scholar]
- Zúbrik, M.; Kunca, A.; Vakula, J.; Galko, J.; Leontovyč, R.; Konôpka, B.; Gubka, A.; Nikolov, C.H.; Rell, S.; Longauerová, V.; et al. Hmyz a Huby: Atlas Poškodení Lesných Drevín, 2nd ed.; National Forest Centre, Forest Research Institute: Zvolen, Slovakia, 2019; 243p. [Google Scholar]
- Longauerová, V.; Maľová, M.; Kunca, A. Poznatky z hynutia jaseňov spôsobovaného hubou Hymenoscyphus pseudoalbidus (ana. Chalara fraxinea). In Aktuálne Problémy v Ochrane Lesa 2013; Kunca, A., Ed.; National Forest Centre: Zvolen, Slovakia, 2013; pp. 77–81. [Google Scholar]
- Pastirčáková, K.; Ivanová, H.; Pastirčák, M. Species diversity of fungi on damaged branches and leaves of ashes (Fraxinus spp.) in different types of stands in Slovakia. Cent. Eur. For. J. 2018, 64, 133–139. [Google Scholar] [CrossRef] [Green Version]
- Kádasi Horáková, M.; Barta, M.; Adamčíková, K.; Ostrovský, R.; Pastirčáková, K. Hymenoscyphus fraxineus on Fraxinus excelsior in Slovakia: Distribution and mating types. Biologia 2022. [Google Scholar] [CrossRef]
- Zhao, Y.-J.; Hosoya, T.; Baral, H.-O.; Hosaka, K.; Kakishima, M. Hymenoscyphus pseudoalbidus, the correct name for Lambertella albida reported from Japan. Mycotaxon 2012, 122, 25–41. [Google Scholar] [CrossRef]
- Gross, A.; Holdenrieder, O.; Pautasso, M.; Queloz, V.; Sieber, T.N. Hymenoscyphus pseudoalbidus, the causal agent of European ash dieback. Mol. Plant Pathol. 2014, 15, 5–21. [Google Scholar] [CrossRef]
- Cleary, M.; Nguyen, D.; Marčiulynienė, D.; Berlin, A.; Vasaitis, R.; Stenlid, J. Friend or foe? Biological and ecological traits of the European ash dieback pathogen Hymenoscyphus fraxineus in its native environment. Sci. Rep. 2016, 6, 21895. [Google Scholar] [CrossRef] [PubMed] [Green Version]
- Hyde, K.D.; Soytong, K. The Fungal Endophyte Dilemma. Fungal Divers 2008, 33, 163–173. [Google Scholar]
- Wilson, D. Endophyte: The Evolution of a Term, and Clarification of Its Use and Definition. Oikos 1995, 73, 274–276. [Google Scholar] [CrossRef]
- Saikkonen, K.; Faeth, S.H.; Helander, M.; Sullivan, T.J. Fungal Endophytes: A Continuum of Interactions with Host Plants. Annu. Rev. Ecol. Syst. 1998, 29, 319–343. [Google Scholar] [CrossRef]
- Redman, R.S.; Sheehan, K.B.; Stout, R.G.; Rodriguez, R.J.; Henson, J.M. Thermotolerance Generated by Plant/Fungal Symbiosis. Science 2002, 298, 1581. [Google Scholar] [CrossRef] [PubMed]
- Arnold, A.E.; Mejía, L.C.; Kyllo, D.; Rojas, E.I.; Maynard, Z.; Robbins, N.; Herre, E.A. Fungal endophytes limit pathogen damage in a tropical tree. Proc. Natl. Acad. Sci. USA 2003, 100, 15649–15654. [Google Scholar] [CrossRef] [Green Version]
- Rodriguez, R.J.; Redman, R.S.; Henson, J.M. The Role of Fungal Symbioses in the Adaptation of Plants to High Stress Environments. Mitig. Adapt. Strateg. Glob. Chang. 2004, 9, 261–272. [Google Scholar] [CrossRef]
- Gao, F.K.; Dai, C.C.; Liu, X.Z. Mechanisms of fungal endophytes in plant protection against pathogens. Afr. J. Microbiol. Res. 2010, 4, 1346–1351. [Google Scholar]
- Mengistu, A.A. Endophytes: Colonization, Behaviour, and Their Role in Defense Mechanism. Int. J. Microbiol. 2020, 2020, 6927219. [Google Scholar] [CrossRef]
- González-Teuber, M.; Vilo, C.; Guevara-Araya, M.J.; Salgado-Luarte, C.; Gianoli, E. Leaf resistance traits influence endophytic fungi colonization and community composition in a South American temperate rainforest. J. Ecol. 2020, 108, 1019–1029. [Google Scholar] [CrossRef]
- Pujade-Renaud, V.; Déon, M.; Gazis, R.; Ribeiro, S.; Dessailly, F.; Granet, F.; Chaverri, P. Endophytes from Wild Rubber Trees as Antagonists of the Pathogen Corynespora cassiicola. Phytopathology 2019, 109, 1888–1899. [Google Scholar] [CrossRef] [PubMed]
- Schlegel, M.; Dubach, V.; Von Buol, L.; Sieber, T.N. Effects of endophytic fungi on the ash dieback pathogen. FEMS Microbiol. Ecol. 2016, 92, fiw142. [Google Scholar] [CrossRef] [PubMed]
- Haňáčková, Z.; Havrdová, L.; Černý, L.; Zahradník, D.; Koukol, O. Fungal endophytes in ash shoots—Diversity and inhibition of Hymenoscyphus fraxineus. Balt. For. 2017, 23, 89–106. [Google Scholar]
- Kosawang, C.; Amby, D.B.; Bussaban, B.; McKinney, L.V.; Xu, J.; Kjær, E.D.; Collinge, D.B.; Nielsen, L.R. Fungal communities associated with species of Fraxinus tolerant to ash dieback, and their potential for biological control. Fungal Biol. 2018, 122, 110–120. [Google Scholar] [CrossRef] [PubMed]
- Becker, R.; Ulrich, K.; Behrendt, U.; Kube, M.; Ulrich, A. Analyzing Ash Leaf-Colonizing Fungal Communities for Their Biological Control of Hymenoscyphus fraxineus. Front. Microbiol. 2020, 11, 590944. [Google Scholar] [CrossRef]
- Halecker, S.; Wennrich, J.-P.; Rodrigo, S.; Andrée, N.; Rabsch, L.; Baschien, C.; Steinert, M.; Stadler, M.; Surup, F.; Schulz, B. Fungal endophytes for biocontrol of ash dieback: The antagonistic potential of Hypoxylon rubiginosum. Fungal Ecol. 2020, 45, 100918. [Google Scholar] [CrossRef]
- Kowalski, T.; Bilański, P. Fungi Detected in the Previous Year’s Leaf Petioles of Fraxinus excelsior and Their Antagonistic Potential against Hymenoscyphus fraxineus. Forests 2021, 12, 1412. [Google Scholar] [CrossRef]
- Nawrot-Chorabik, K.; Marcol-Rumak, N.; Latowski, D. Investigation of the Biocontrol Potential of Two Ash Endophytes against Hymenoscyphus fraxineus Using In Vitro Plant–Fungus Dual Cultures. Forests 2021, 12, 1750. [Google Scholar] [CrossRef]
- Bilański, P.; Kowalski, T. Fungal endophytes in Fraxinus excelsior petioles and their in vitro antagonistic potential against the ash dieback pathogen Hymenoscyphus fraxineus. Microbiol. Res. 2022, 257, 126961. [Google Scholar] [CrossRef]
- Collinge, D.B.; Jørgensen, H.J.L.; Latz, M.A.C.; Manzotti, A.; Ntana, F.; Rojas, E.C.; Jensen, B. Searching for novel fungal biological control agents for plant disease control among endophytes. In Endophytes for a Growing World, 1st ed.; Hodkinson, T., Doohan, F., Saunders, M., Murphy, B., Eds.; Cambridge University Press: Cambridge, UK, 2019; pp. 25–51. [Google Scholar] [CrossRef] [Green Version]
- Ivanová, H. Identification and characterization of the fungus Dothiorella sarmentorum on necrotic shoots of declining ash in Slovakia. Folia Oecol. 2018, 45, 53–57. [Google Scholar] [CrossRef] [Green Version]
- Ivanova, H.; Malinicova, L.; Piknova, M.; Pristas, P. New Endophytic Fusarium spp. from Fraxinus excelsior Leaves in Slovakia. Planta Med. 2020, 86, 1025–1031. [Google Scholar] [CrossRef] [PubMed]
- Adamčíková, K.; Kádasi-Horáková, M.; Jankovský, L.; Havrdová, L. Identification of Hymenoscyphus fraxineus, the causal agent of ash dieback in Slovakia. Biologia 2015, 70, 559–564. [Google Scholar] [CrossRef]
- Adamčíková, K.; Pažitný, J.; Pastirčáková, K. Individual resistance of Fraxinus angustifolia and F. excelsior clones to Hymenoscyphus fraxineus. J. Plant Protect. Res. 2018, 58, 227–233. [Google Scholar]
- Kirisits, T.; Dämpfle, L.; Kräutler, K. Hymenoscyphus albidus is not associated with an anamorphic stage and displays slower growth than Hymenoscyphus pseudoalbidus on agar media. For. Pathol. 2013, 43, 386–389. [Google Scholar] [CrossRef]
- Ibrahim, M.; Sieber, T.N.; Schlegel, M. Communities of fungal endophytes in leaves of Fraxinus ornus are highly diverse. Fungal Ecol. 2017, 29, 10–19. [Google Scholar] [CrossRef]
- Kumar, D.S.S.; Hyde, K.D. Biodiversity and tissue-recurrence of endophytic fungi in Tripterygium wilfordii. Fungal Divers. 2004, 17, 69–90. [Google Scholar]
- White, T.J.; Bruns, T.; Lee, S.; Taylor, J. Amplification and direct sequencing of fungal ribosomal RNA genes for phylogenetics. In PCR Protocols: A Guide to Methods and Applications, 1st ed.; Innis, M.A., Gelfand, D.H., Sninsky, J.J., White, T.J., Eds.; Academic Press: San Diego, CA, USA, 1990; pp. 315–322. [Google Scholar] [CrossRef]
- Gardes, M.; Bruns, T.D. ITS primers with enhanced specificity for basidiomycetes—Application to the identification of mycorrhizae and rusts. Mol. Ecol. 1993, 2, 113–118. [Google Scholar] [CrossRef]
- Kádasi-Horáková, M.; Adamčíková, K.; Pastirčáková, K.; Longauerová, V.; Maľová, M. Natural infection of Fraxinus angustifolia by Hymenoscyphus fraxineus in Slovakia. Balt. For. 2017, 23, 52–55. [Google Scholar]
- Zhang, Z.; Schwartz, S.; Wagner, L.; Miller, W. A Greedy Algorithm for Aligning DNA Sequences. J. Comput. Biol. 2000, 7, 203–214. [Google Scholar] [CrossRef]
- Abdallah, M.F.; De Boevre, M.; Landschoot, S.; De Saeger, S.; Haesaert, G.; Audenaert, K. Fungal Endophytes Control Fusarium graminearum and Reduce Trichothecenes and Zearalenone in Maize. Toxins 2018, 10, 493. [Google Scholar] [CrossRef] [Green Version]
- Skidmore, A.M.; Dickinson, C.H. Colony interactions and hyphal interference between Septoria nodorum and phylloplane fungi. Trans. Br. Mycol. Soc. 1976, 66, 57–64. [Google Scholar] [CrossRef]
- Gross, A.; Sieber, T.N. Virulence of Hymenoscyphus albidus and native and introduced Hymenoscyphus fraxineus on Fraxinus excelsior and Fraxinus pennsylvanica. Plant Pathol. 2016, 65, 655–663. [Google Scholar] [CrossRef]
- Johansson, S.B.K.; Vasaitis, R.; Ihrmark, K.; Barklund, P.; Stenlid, J. Detection of Chalara fraxinea from tissue of Fraxinus excelsior using species-specific ITS primers. For. Pathol. 2010, 40, 111–115. [Google Scholar] [CrossRef]
- Pastirčáková, K.; Adamčíková, K.; Barta, M.; Pažitný, J.; Hoťka, P.; Sarvašová, I.; Kádasi Horáková, M. Host Range of Hymenoscyphus fraxineus in Slovak Arboreta. Forests 2020, 11, 596. [Google Scholar] [CrossRef]
- Shannon, C.E. A Mathematical Theory of Communication. Bell Syst. Tech. J. 1948, 27, 379–423. [Google Scholar] [CrossRef] [Green Version]
- Simpson, E.H. Measurement of Diversity. Nature 1949, 163, 668. [Google Scholar] [CrossRef]
- Camargo, J.A. On Measuring Species Evenness and Other Associated Parameters of Community Structure. Oikos 1995, 74, 538–542. [Google Scholar] [CrossRef]
- Scholtysik, A.; Unterseher, M.; Otto, P.; Wirth, C. Spatio-temporal dynamics of endophyte diversity in the canopy of European ash (Fraxinus excelsior). Mycol. Prog. 2013, 12, 291–304. [Google Scholar] [CrossRef]
- Schlegel, M.; Queloz, V.; Sieber, T.N. The Endophytic Mycobiome of European Ash and Sycamore Maple Leaves—Geographic Patterns, Host Specificity and Influence of Ash Dieback. Front. Microbiol. 2018, 9, 2345. [Google Scholar] [CrossRef]
- Osono, T.; Mori, A. Seasonal and leaf age-dependent changes in occurrence of phyllosphere fungi of giant dogwood. Mycoscience 2005, 46, 273–279. [Google Scholar] [CrossRef]
- Guo, L.-D.; Huang, G.-R.; Wang, Y. Seasonal and Tissue Age Influences on Endophytic Fungi of Pinus tabulae formis (Pinaceae) in the Dongling Mountains, Beijing. J. Integr. Plant Biol. 2008, 50, 997–1003. [Google Scholar] [CrossRef] [PubMed]
- Juybari, H.Z.; Ghanbary, M.A.T.; Rahimian, H.; Karimi, K.; Arzanlou, M. Seasonal, tissue and age influences on frequency and biodiversity of endophytic fungi of Citrus sinensis in Iran. For. Pathol. 2019, 49, e12559. [Google Scholar] [CrossRef]
- Sadeghi, F.; Samsampour, D.; Seyahooei, M.A.; Bagheri, A.; Soltani, J. Diversity and Spatiotemporal Distribution of Fungal Endophytes Associated with Citrus reticulata cv. Siyahoo. Curr. Microbiol. 2019, 76, 279–289. [Google Scholar] [CrossRef] [PubMed]
- Sieber, T.N. The phyllosphere mycobiome of woody plants. In Forest Microbiology, 1st ed.; Tree Microbiome: Phyllosphere, Endosphere and Rhizosphere; Asiegbu, F.O., Kovalchuk, A., Eds.; Academic Press: London, UK, 2021; Volume 1, pp. 111–132. [Google Scholar] [CrossRef]
- Pan, J.J.; May, G. Fungal-Fungal Associations Affect the Assembly of Endophyte Communities in Maize (Zea mays). Microb. Ecol. 2009, 58, 668–678. [Google Scholar] [CrossRef] [PubMed]
- Rabiey, M.; Hailey, L.E.; Roy, S.R.; Grenz, K.; Al-Zadjali, M.A.S.; Barrett, G.A.; Jackson, R.W. Endophytes vs tree pathogens and pests: Can they be used as biological control agents to improve tree health? Eur. J. Plant Pathol. 2019, 155, 711–729. [Google Scholar] [CrossRef] [Green Version]
- Ownley, B.H.; Pereira, R.M.; Klingeman, W.E.; Quigley, N.B.; Leckie, B.M. Beauveria bassiana, a dual purpose biological control with activity against insect pests and plant pathogens. In Emerging Concepts in Plant Health Management, 1st ed.; Lartey, R.T., Caesar, A.J., Eds.; Research Signpost: Thiruvananthapuram, India, 2004; pp. 255–269. [Google Scholar]
- Anjum, R.; Afzal, M.; Baber, R.; Khan, M.A.J.; Kanwal, W.; Sajid, W.; Raheel, A. Endophytes: As Potential Biocontrol Agent—Review and Future Prospects. J. Agric. Sci. 2019, 11, 113. [Google Scholar] [CrossRef] [Green Version]
- De Silva, N.I.; Brooks, S.; Lumyong, S.; Hyde, K.D. Use of endophytes as biocontrol agents. Fungal Biol. Rev. 2019, 33, 133–148. [Google Scholar] [CrossRef]
- Bamisile, B.S.; Siddiqui, J.A.; Akutse, K.S.; Ramos Aguila, L.C.; Xu, Y. General Limitations to Endophytic Entomopathogenic Fungi Use as Plant Growth Promoters, Pests and Pathogens Biocontrol Agents. Plants 2021, 10, 2119. [Google Scholar] [CrossRef]
- Ganley, R.J.; Sniezko, R.A.; Newcombe, G. Endophyte-mediated resistance against white pine blister rust in Pinus monticola. For. Ecol. Manag. 2008, 255, 2751–2760. [Google Scholar] [CrossRef]
- Berger, G.; Czarnocka, K.; Cochard, B.; Oszako, T.; Lefort, F. Biocontrol Endotherapy with Trichoderma spp. and Bacillus amyloliquefaciens against Phytophthora spp.: A Comparative Study with Phosphite Treatment on Quercus robur and Fagus sylvatica. J. Agric. Sci. Technol. 2015, 5, 428–439. [Google Scholar] [CrossRef] [Green Version]
- Poveda, J.; Baptista, P. Filamentous fungi as biocontrol agents in olive (Olea europaea L.) diseases: Mycorrhizal and endophytic fungi. Crop Prot. 2021, 146, 105672. [Google Scholar] [CrossRef]
- Marcol, N.; Pukalski, J.; NawrotChorabik, K.; Kowalski, T.; Latowski, D. Will black pigments save European ash (Fraxinus excelsior L.)?—EPR analysis of melanin production in dual-culture of endophytic and pathogenic fungi. In Proceedings of the 45th FEBS Congress, Molecules of Life: Towards New Horizons, Ljubljana, Slovenia, 3–8 July 2021. [Google Scholar]
- Tsantrizos, Y.S.; Xu, X.-J.; Sauriol, F.; Hynes, R.C. Novel quinazolinones and enniatins from Fusarium lateritium Nees. Can. J. Chem. 1993, 71, 1362–1367. [Google Scholar] [CrossRef]
- Gerlach, W.; Nirenberg, H. The Genus Fusarium, a Pictorial Atlas, 1st ed.; Mitt. Biol. Bundesanst. Land-Forstwirsch. Berlin-Dahlem; Kommissionsverlag P. Parey: Berlin, Germany, 1982; Volume 209, 406p. [Google Scholar] [CrossRef]
- Vitale, S.; Santori, A.; Wajnberg, E.; Castagnone-Sereno, P.; Luongo, L.; Belisario, A. Morphological and Molecular Analysis of Fusarium lateritium, the Cause of Gray Necrosis of Hazelnut Fruit in Italy. Phytopathology 2011, 101, 679–686. [Google Scholar] [CrossRef] [PubMed] [Green Version]
- Yu, Z.D.; Gao, A.Q. Pathogenicity of Dothiorella gregaria to Rosaceae and other host trees. For. Pest Dis. 2004, 23, 21–23. [Google Scholar]
- Chen, Q.; Jiang, J.; Zhang, G.; Cai, L.; Crous, P. Resolving the Phoma enigma. Stud. Mycol. 2015, 82, 137–217. [Google Scholar] [CrossRef] [Green Version]
- Farr, D.F.; Rossman, A.Y. Fungal Databases, U.S. National Fungus Collections, ARS, USDA. Available online: https://nt.ars-grin.gov/fungaldatabases/ (accessed on 15 May 2022).
Publisher’s Note: MDPI stays neutral with regard to jurisdictional claims in published maps and institutional affiliations. |
© 2022 by the authors. Licensee MDPI, Basel, Switzerland. This article is an open access article distributed under the terms and conditions of the Creative Commons Attribution (CC BY) license (https://creativecommons.org/licenses/by/4.0/).






